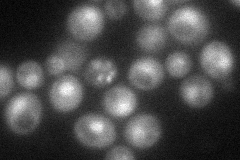
YER171W
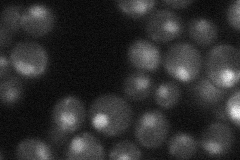
YER171W
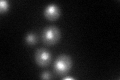
YER171W
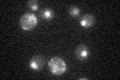
YER171W

View description
5' to 3' DNA helicase, involved in nucleotide excision repair and transcription; subunit of RNA polymerase II transcription initiation factor TFIIH; subunit of Nucleotide Excision Repair Factor 3 (NEF3); homolog of human XPD protein
Localization:
Intensity:
Fold change:
Significance:
-
C’ GFP library in SD

nucleus32.08 -
N' NOP1pr-GFP in SD
cytosol,nucleus61.5332 -
N' TEF2pr-mCherry in SD

cytosol,nucleus24.7766 -
N' NATIVEpr-GFP in SD
nucleus31.6353 -
N' TEF2pr-VC and Cyto-VN in SD

nucleus27.6239 -
C’ GFP library in SD+DTT
nucleusN/AN/AYes -
C’ GFP library in SD+H2O2

technical problem0N/ANo -
C’ GFP library in Starvation Media
nucleusN/AN/AYes -
C’ GFP library on the background of Pup2-DaMP

N/A -
C’ GFP library on the background of CCT mutant

N/A0N/AYes
